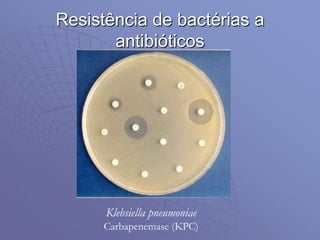
Resistência de bactérias a
antibióticos
Klebsiella pneumoniae
Carbapenemase (KPC)

Este documento discute as principais teorias da evolução biológica, incluindo o fixismo, as ideias de Lamarck e Darwin, e a síntese evolutiva moderna. Resume os princípios do darwinismo como a variação, hereditariedade e seleção natural, e como a genética moderna integrou essas ideias na teoria sintética da evolução.